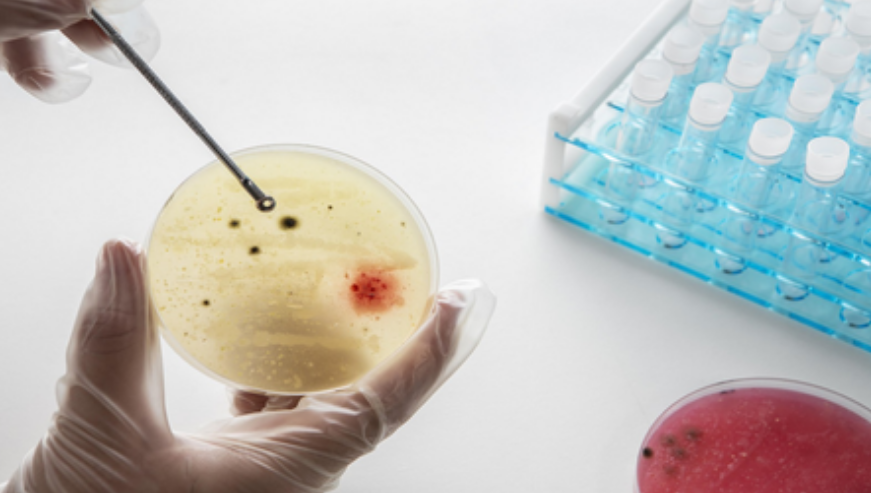

Airborne Pathogens Twice as Prevalent in Crowded Cities, Study Finds
NEW DELHI– Airborne pathogens that trigger infections in the lungs, gut, mouth, and skin are found at nearly double the levels in densely populated urban areas compared to less crowded regions, according to new research from the Bose Institute.
The study, published in the journal Atmospheric Environment: X, examined the health risks of airborne pathogens in Delhi, one of the world’s most polluted and heavily populated metropolitan centers. Researchers found that fine particulate matter (PM2.5) plays a critical role in spreading bacteria through the air.
“PM2.5—the microscopic dust specks—help bacteria hitch a ride through the city air,” said lead researcher Dr. Sanat Kumar Das. Because the particles are small enough to penetrate deep into the lungs, they serve as carriers for infectious microbes, enabling them to spread more widely throughout the body.
Delhi’s geography on the Indo-Gangetic Plain, combined with severe air pollution, makes the city particularly vulnerable. Winter conditions, including sharp temperature drops and higher humidity caused by western disturbances, often trap pollutants close to the ground, creating an environment where airborne microbes accumulate.
“The transition from winter to summer, especially during hazy days or winter rains, creates high-risk windows when airborne diseases are more likely to spread,” the researchers noted. During these periods, a mix of weather patterns and pollution allows microbes to persist longer in the atmosphere.
Previous studies have shown spikes in airborne microbial populations over northern India in winter, but limited research had connected meteorology, pollution, and population density to health risks. The Bose Institute team says their findings should serve as “a wake-up call for urban health planning.”
“Megacities like Delhi, where millions breathe polluted air daily, may also be exposing residents to invisible bacterial communities enriched with pathogens,” the researchers said. They added that better understanding of these dynamics could help governments predict outbreaks, design healthier urban spaces, and protect public health. (Source: IANS)



